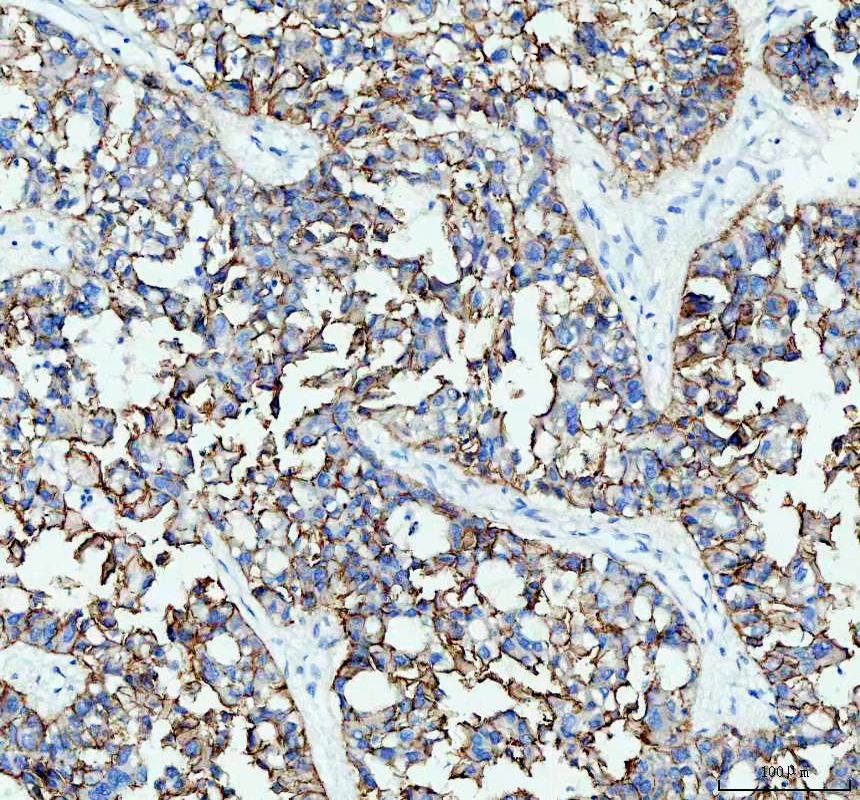

| 组分 | 规格 |
|---|---|
| 5% BSA 封闭液 | 3ml/6ml/12ml/50ml/100ml |
| 聚合 HRP 标记抗小鼠 IgG | 3ml/6ml/12ml/50ml/100ml |
| 3% H2O2 | 3ml/6ml/12ml/50ml/100ml |

IHC analysis of E-cadherin/CDH1 using anti-E-cadherin/CDH1 antibody (M00063-2).
E-cadherin/CDH1 was detected in a paraffin-embedded section of human liver cancer tissue. The tissue section was incubated with mouse anti-E-cadherin/CDH1 Antibody (M00063-2) at a dilution of 1:200 and developed using HRP Conjugated mouse IgG Super Vision Assay Kit (Catalog # SV0001) with DAB (Catalog # AR1022) as the chromogen.

IHC analysis of E-cadherin/CDH1 using anti-E-cadherin/CDH1 antibody (M00063-2).
E-cadherin/CDH1 was detected in a paraffin-embedded section of human liver cancer tissue. The tissue section was incubated with mouse anti-E-cadherin/CDH1 Antibody (M00063-2) at a dilution of 1:200 and developed using HRP Conjugated mouse IgG Super Vision Assay Kit (Catalog # SV0001) with DAB (Catalog # AR1022) as the chromogen.